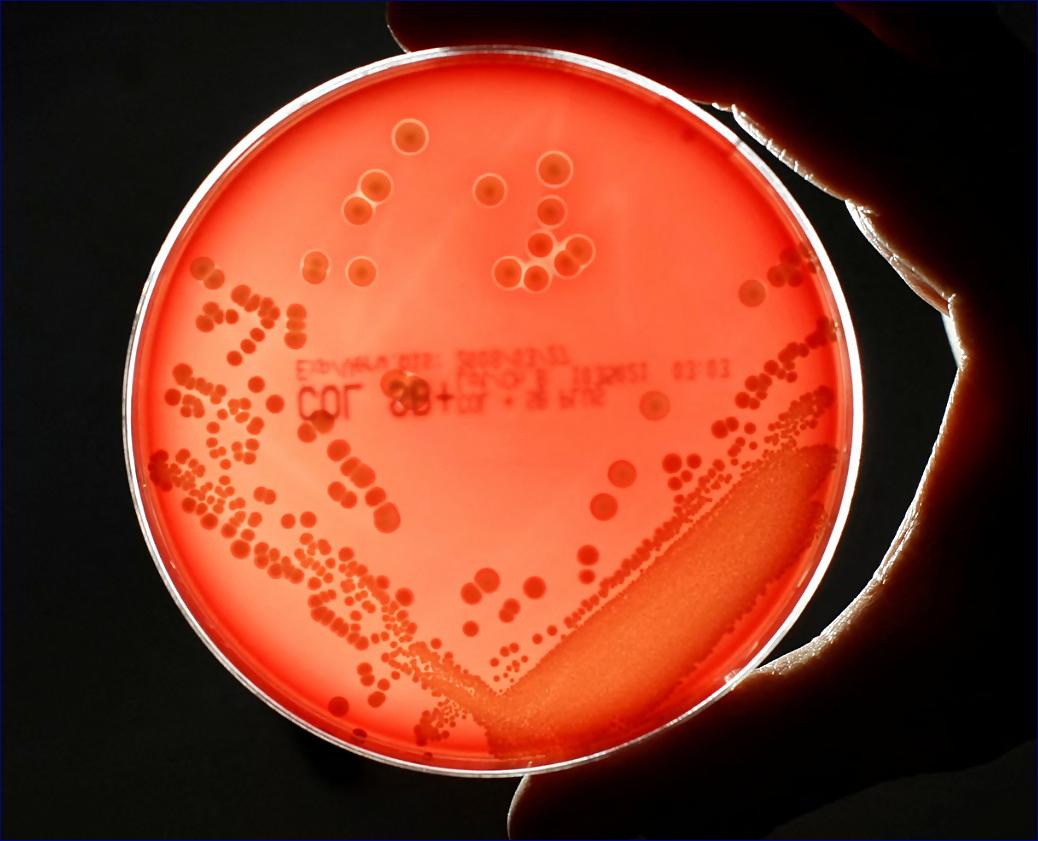

Světová zdravotnická organizace zjistila prudký globální nárůst infekcí rezistentních na antibiotika v nemocnicích
14. 10. 2025
Odborníci popisují tyto zjištění jako velmi znepokojivé a předpovídají 70% nárůst souvisejících úmrtí do roku 2050
Nemocnice po celém světě zaznamenaly alarmující nárůst běžných infekcí rezistentních na antibiotika a lékaři tvrdí, že počet úmrtí způsobených rezistencí na léky v příštích letech prudce vzroste.
V roce 2023 byla rezistentní na antibiotickou léčbu jedna ze šesti laboratorně potvrzených bakteriálních infekcí, přičemž více než 40 % antibiotik ztratilo mezi lety 2018 a 2023 účinnost proti běžným infekcím krve, střev, močových cest a pohlavně přenosným infekcím, jak vyplývá z údajů.
Podle zprávy Světové zdravotnické organizace o globálním sledování rezistence na antibiotika, která shromáždila údaje o více než 23 milionech bakteriálních infekcí ze 104 zemí, byl tento problém nejzávažnější a zhoršoval se v zemích s nízkými a středními příjmy a v zemích se slabším zdravotním systémem.
„Tato zjištění jsou velmi znepokojivá,“ řekl Dr. Yvan Hutin, ředitel oddělení antimikrobiální rezistence Světové zdravotnické organizace. „Vzhledem k tomu, že rezistence vůči antibiotikům stále roste, docházejí nám možnosti léčby a ohrožujeme životy, zejména v zemích, kde je prevence a kontrola infekcí slabá a přístup k diagnostice a účinným lékům je již omezený.“
Odhady rezistence pro některé země mohou být zkreslené, protože zdravotnické systémy vykazují údaje pouze od specializovaných nemocnic, které léčí nejzávažnější infekce. Na základě shromážděných údajů však WHO odhaduje, že v roce 2023 byla jedna ze tří bakteriálních infekcí v jihovýchodní Asii a východním Středomoří rezistentní na antibiotika a jedna z pěti v Africe.
Antimikrobiální rezistence (AMR) vzniká, když se patogeny vyvinou tak, že odolávají lékům používaným k jejich ničení. V roce 2021 zemřelo na bakteriální infekce celosvětově 7,7 milionu lidí. Rezistence na léky přispěla k 4,71 milionu úmrtí, z toho 1,14 milionu přímo.
Zpráva vyvolává vážné obavy ohledně gramnegativních bakterií – těch, které jsou chráněny vnější vrstvou – jako jsou Escherichia coli a Klebsiella pneumoniae, které způsobují některé z nejzávažnějších bakteriálních infekcí, které často vedou k sepsi, selhání orgánů a smrti.
Hutin uvedl, že 40 % bakterií E. coli a více než 55 % bakterií K. pneumoniae je rezistentních na cefalosporiny třetí generace, které jsou první volbou při léčbě těchto infekcí. V africkém regionu WHO rezistence často přesahuje 70 %, uvedl.
Zpráva také zjistila, že rezistence vůči kritickým antibiotikům druhé volby, zejména karbapenemům a fluorochinolonům, rostla také u klíčových gramnegativních bakterií, jako jsou Acinetobacter, K pneumoniae a salmonella. „Tato antibiotika jsou kriticky důležitá pro léčbu závažných infekcí a jejich rostoucí neúčinnost zužuje možnosti léčby,“ uvedl Hutin.
Dr. Manica Balasegaram z Global Antibiotic Research and Development Partnership uvedl, že zpráva přispěla k důkazům, že infekce rezistentní na léky dosáhly „kritického bodu zlomu“.
„Nejobtížněji léčitelné gramnegativní infekce nyní začínají předstihovat vývoj antibiotik, buď proto, že správná antibiotika se nedostávají k lidem, kteří je potřebují, nebo proto, že se vůbec nevyvíjejí,“ uvedl. „V důsledku toho se nyní očekává prudký nárůst počtu úmrtí v důsledku AMR, který do roku 2050 vzroste o 70 %.
„Nestačí vyvíjet nová antibiotika, musí to být ta správná antibiotika, která se zaměřují na infekce s největším dopadem na veřejné zdraví. Nedaří se nám nahradit antibiotika, která se ztrácejí v důsledku rezistence, a tato nejnovější zpráva WHO ukazuje, že důsledky toho se nyní konečně začínají projevovat.
„Dosud se diskuse o AMR správně soustředila na nadužívání antibiotik, ale to nestačí. Abychom se vyhnuli bodu zlomu, musíme nyní také zaměřit úsilí na urychlení inovací a zvýšení jejich vhodného používání.“
Profesor Sanjib Bhakta, který se zabývá léky na boj proti AMR na University College London, uvedl, že zpráva WHO odhalila „alarmující nárůst rezistence“, zejména u gramnegativních bakterií.
Uvedl, že boj proti AMR vyžaduje „cílené globální opatření“, od posílení dohledu a diagnostiky až po zajištění spravedlivého přístupu k antibiotikům s úzkým spektrem účinku. Důležitá je také prevence infekcí prostřednictvím čistší vody, lepší hygieny a očkování.
Diskuse